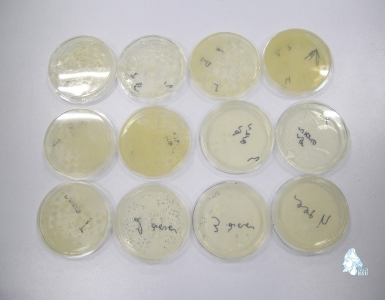
სურათი

29 ივლისიდან 3 აგვისტოს ჩათვლით, კომპანია „ბიოლოგიკა“ და ბათუმის შოთა რუსთაველის სახელმწიფო უნივერსიტეტი ერთობლივად ატარებს საერთაშორისო საზაფხულო სკოლას ბიოსამედიცინო მიმართულებით. სწავლების განმავლობაში მსმენელებს უტარდებათ, როგორც თეორიული, ისე პრაქტიკული მეცადინეობები მიკრობილოგიაში, იმუნოლოგიასა და ბიოქიმიაში. სწავლების საბაზო მასალას წარმოადგენს უნიკალური კრებულები, რომლებიც არის კომპანიის მიერ შექმნილი.
სწავლებას უძღვება საქართველოს ტექნიკური უნივერსიტეტის სრული პროფესორი ბიოლოგიის მეცნიერებათა დოქტორი ედიშერ კვესიტაძე. სკოლის მუშაობაში ჩართულია ბათუმის სახელმწიფო უნივერსიტეტის ქიმიის დეპარტამენტი და მონაწილეობას ღებულობენ საქართველოს სხვადასხვა უნივერსიტეტისა და სკოლის პედაგოგები, დოქტორანტები, მაგისტრები, რომლებიც დაინტერესებული არიან საბუნებისმეტყველო მიმართულებით სწავლებაში კვლევითი კომპონენტის ინტეგრირებით. ერთკვირიანი სწავლების შემდეგ მონაწილეებს გადაეცემათ სერტიფიკატები.
| უკან |